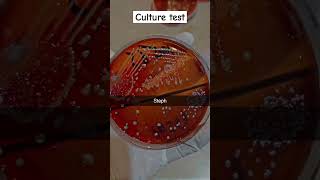

Shared 11 months ago
586 views
Shared 1 year ago
5K views
Shared 11 months ago
117 views
Shared 2 years ago
9.7K views
Shared 4 years ago
598 views
Shared 3 years ago
42 views
Shared 4 years ago
1.3K views
Shared 4 years ago
1K views
Shared 2 months ago
195 views
Shared 1 week ago
13K views
Shared 2 months ago
493 views
Shared 9 months ago
873 views
Shared 4 years ago
135 views
Shared 2 months ago
295 views
Shared 4 years ago
223 views
Shared 4 years ago
340 views
Shared 4 years ago
138 views
Shared 7 months ago
310 views
Shared 2 years ago
1.6K views
Shared 2 years ago
52 views
Shared 4 years ago
230 views
Shared 3 years ago
292 views
Shared 1 year ago
92 views
Shared 1 year ago
138 views
Shared 2 years ago
123 views
Shared 1 year ago
1.6K views
Your Guide to Medical Lab Technologist Jobs & Immigration #mltjobs #medicallabtech #canadaworkpermit
Shared 1 year ago
164 views
Shared 1 year ago
171 views
Shared 3 months ago
12 views
Urine analysis test . #laboratory #fact #lab #medicallabtechnologist #laboratory_technician #biology
Shared 2 years ago
104 views
Shared 2 years ago
64 views